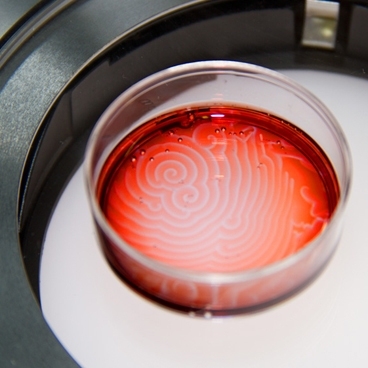

Video: Melanie Gonick; additional footage: Irene Chen
Self-oscillating gels are materials that continuously change back and forth between different states — such as color or size — without provocation from external stimuli. These changes are caused by the Belousov-Zhabotinsky chemical reaction, which was discovered during the 1950s. Without stirring or other outside influence, wave patterns from this chemical reaction can develop within the material or cause the entire gel itself to pulsate.
Irene Chou Chen, a doctoral candidate in the lab of Krystyn J. Van Vliet, the Paul M. Cook Career Development Associate Professor of Materials Science and Engineering, has been studying exactly how adjusting the size and shape of these gels can affect their behavior.
By integrating experiments with computer simulations conducted by collaborators Olga Kuksenok, Victor Yashin and Anna C. Balazs at the University of Pittsburgh, the MIT researchers have shown that pattern formation within the material can be controlled by changing the gel's size or shape. When the reaction is restricted to a sub-millimeter-sized gel, the material exhibits chemical oscillations that cause it to mechanically swell and shrink. Lasting for several hours, these self-sustained oscillations exemplify chemomechanical coupling — where chemical reactions cause mechanical changes. The work will be published in the March issue of the journal Soft Matter as part of a special focus on “active soft matter.”
The self-sustained pulsations could enable unique applications for this material, the researchers say, such as using it as an environmental sensor or as an actuator that could react to specific conditions. The simulations developed by the University of Pittsburgh group could also help to make such applications easier to implement.